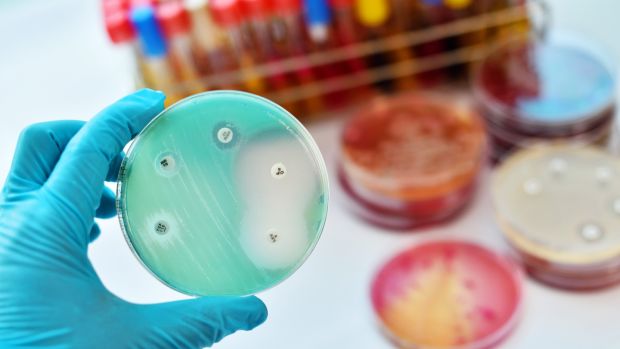
Mạng thần kinh nh&acirc;n tạo t&igrave;m ra kh&aacute;ng sinh ti&ecirc;u diệt được loại vi khuẩn mọi thuốc kh&aacute;c phải b&oacute; tay, đặt ra th&ecirc;m c&acirc;u hỏi kh&oacute; cho khoa học - Ảnh 3.

Mạng thần kinh nhân tạo tìm ra kháng sinh tiêu diệt được loại vi khuẩn mọi thuốc khác phải bó tay, đặt ra thêm câu hỏi khó cho khoa học
Sức mạnh của máy tính đưa ngành y lên một tầm cao mới.
- Nghiên cứu khoa học: Sự sống có thể tồn tại rất nhiều nơi trong Vũ trụ, nó chỉ không nằm trong vùng ta quan sát được mà thôi
- Nhận định lạc quan của giáo sư đoạt giải Nobel dự báo như thần dịch Covid-19
- Báo Mỹ: Phát hiện triệu chứng cực kỳ đơn giản để xác định người nghi nhiễm COVID-19 kể cả khi chưa phát bệnh
Gần 100 năm trước, Alexander Fleming phát hiện ra thuốc kháng sinh và trực tiếp cứu được cả triệu người. Quá trình nghiên cứu thuốc thời bấy giờ vẫn vất vả và mù mờ, như lờ Fleming đã nói đây: “Tôi chơi đùa với vi khuẩn thôi. Cũng cảm thấy hạnh phúc khi có thể phá bỏ các quy tắc rồi tìm thấy được thứ chưa ai phát hiện ra”.
Công cuộc nghiên cứu kháng sinh ngày nay thì khác, không còn phải ngồi “chơi đùa” với vi khuẩn với mong muốn ngẫu nhiên tìm ra được thứ thuốc cứu rỗi nhân loại. Ngày nay, ta tìm tới sức mạnh tính toán siêu việt của những cỗ máy.
Trong báo cáo khoa học được đăng tải trên tạp chí Cell, các nhà khoa học tại Viện Công nghệ Massachusetts mô tả cách họ sử dụng mạng neural để xác định một hợp chất thuốc khác biệt với đại đa số các kháng sinh có trong ngành y. Kết quả nghiên cứu khả quan vô cùng: khi thử nghiệm thứ thuốc mới trên chuột, nhóm các nhà khoa học phát hiện ra rằng nó chống lại được những thứ vi khuẩn không loại thuốc nào trị được.
Khám phá mới có thể giúp ta chống lại được cả virus SARS-CoV-2 đang hoành hành tại nhiều nước trên thế giới.
Với ba điểm lớn sau đây, đột phá mới khiến chúng ta tin rằng trí tuệ nhân tạo sẽ thay đổi bộ mặt ngành y ra sao:
- Sử dụng công nghệ mạng neural thay thế cách thức thử nghiệm cũ.
- Tìm ra ứng dụng của một hợp chất thuốc có sẵn.
- Tìm ra một kháng sinh mới có cơ chế khác với những thuốc ta vẫn biết.
Phân tử kháng sinh mới được đặt tên là “halicin”, theo tên của hệ thống trí tuệ nhân tạo Hal 9000 trong bộ phim 2001: A Space Odyssey. Đã từ lâu, khoa học biết rằng halicin có thể ức chế hoạt động của enzym kinaza (kinase) có thể gây tổn thương gan. Nhưng đến giờ, ta mới biết nó có tác dụng giống kháng sinh.
Đây lại là một ví dụ nữa cho thấy xu hướng mới của ngành y: khám phá ra những tác dụng mới của thuốc cũ.
Halicin ở đĩa hàng trên hiệu quả hơn trong diệt khuẩn E. coli, hơn hẳn kháng sinh hiện tại ở đĩa hàng dưới.
Halicin có khả năng chống lại mầm bệnh có tên Acinetobacter baumannii, hay A. baumannii, một trong những loài khuẩn kháng nhiều loại thuốc và làm bó tay toàn bộ các kháng sinh ta đang có. A. baumannii thường hiện hữu trên các bề mặt trong bệnh viện, tấn công người bệnh ốm nặng và đã quấy rầy ngành y suốt nhiều năm nay. Tổ chức Y tế Thế giới WHO nhấn mạnh rằng A. baumannii là “một trong những mầm bệnh cần được chú ý nhất và cần kháng sinh khẩn cấp”.
Câu hỏi lớn được đặt ra: liệu khám phá này là ngẫu nhiên, hay ta đã tìm ra cách thức khám phá ra loại kháng sinh mới, để đạt được nhiều đột phá hơn trong tương lai gần?
Dựa trên báo cáo nghiên cứu, ta có thể thấy các nhà khoa học dựa trên logic nhiều hơn là may mắn. Họ huấn luyện cho hệ thống AI tạo ra mô hình cấu trúc hóa học của phân tử, và chính mô hình đó chọn ra được hợp chất thuốc hiệu quả nhất mà nó cho là đúng, và kết quả này vốn được khoa học cho là không khả thi.
Để hiểu được logic chọn thuốc của AI, ta cần hiểu được những khó khăn các nhà khoa học đối mặt, và cũng là khó khăn mà nhiều hệ thống trí tuệ nhân tạo phải giải quyết: đó là khám phá đối nghịch với lợi dụng khe hở, tìm cách để mở rộng tầm nhìn để ra được câu trả lời nhưng vẫn dựa trên những gì đã khám phá được.
Nhiều nghiên cứu kháng sinh hiện tại phải đối mặt với vấn đề nan giải trên, đó là nhận định của tác giả bài báo cáo khoa học Jonathan Stokes. Ngành nghiên cứu kháng sinh hoặc tạo ra những phân tử giống với những thứ thuốc đang có sẵn, hoặc lúng túng trong công cuộc tìm thuốc vốn như mò kim đáy bể.
Giải pháp để giải quyết vấn đề là nâng AI lên một tầm cao mới. Giáo sư Stokes và đội ngũ cộng sự đông đảo gồm 19 chuyên gia từ nhiều phòng thí nghiệm của MIT và Harvard đã huấn luyện mạng neural nhận diện những phân tử thuốc có thể và không thể chống lại khuẩn E. coli. Một khi chúng đã biết đâu là thuốc chống được E. coli, mạng neural sẽ tìm trong cơ sở dữ liệu của 6.000 phân tử thuốc đang ở nhiều giai đoạn phát triển khác nhau, tìm ra một loại thuốc có khả năng kháng E. coli, và cỗ máy tìm ra được halicin.
Và đáng ngạc nhiên thay, halicin cũng mang khả năng chống đỡ nhiều loài khuẩn khác nữa, trong đó có A. baumannii. Thử nghiệm cho thấy halicin đẩy lui đáng kể lượng khuẩn có trên chuột; mẫu khuẩn được dùng là A. baumannii CDC 288, có khả năng kháng tất cả những thứ kháng sinh vốn từng được sử dụng để triệt loài khuẩn này.
Halicin không chỉ là thứ kháng sinh không ai ngờ tới, mà thậm chí nó còn mang trong mình cơ chế kháng khuẩn khác thường, lại thêm một đề tài nghiên cứu nữa và thêm dữ liệu cho máy tính phân tích thuốc trong tương lai.
Điểm mấu chốt để tìm ra được khám phá này nằm ở mạng neural, nó không dựa vào những thông tin đã có về cấu trúc hóa học của phân tử, mà tự mình dựng lên những mẫu hình khác để nghiên cứu.
Suốt nhiều năm, khoa học đã dựng được một thư viện những “dấu vân hóa học” của phân tử, bao gồm cả kháng sinh. Chúng là chứng cứ để dự đoán hoạt động của phân tử, ví dụ như xét xem liệu chất có khả năng kháng khuẩn. Nhưng chỉ dựa vào quá trình lâu năm này thì không đủ, nên nghiên cứu mới ứng dụng cả cách thức Chemprop, dựng những vân tay hóa học kia từ con số 0. Nhóm các nhà khoa học tại MIT là những người đứng sau nghiên cứu về Chemprop.
Ngoài việc phát hiện ra halicin, cách thức Chemprop còn tìm ra 8 “hợp chất kháng khuẩn khác với cấu trúc khác xa với kháng sinh thường”, một trong số đó được MIT khuyên nên đưa vào diện ưu tiên nghiên cứu sâu hơn, bởi nó có khả năng triệt tiêu tiêu hoàn toàn khuẩn E. coli khi được thử trong ống nghiệm.
Phương pháp huấn luyện mạng neural mới thậm chí còn khiến ngành y phải đặt dấu hỏi, liệu họ đã biết tường tận cách thức thuốc kháng sinh vận hành. Đây lại là một khía cạnh đáng chú ý nữa mà đột phá mới nêu ra.
Trong lúc khoa học tiếp tục đào sâu tìm hiểu kháng sinh, chúng ta nhận thấy hai tiến bộ lớn, một là phương pháp dựng vân tay hóa học Chemprop và việc phát hiện ra halicin, cả hai đột phá đều cho thấy khả năng vô tận của khám phá khoa học. Ta vừa tìm ra được yếu tố mới dựa trên những kiến thức sẵn có, mà lại vừa mở ra khía cạnh mới để mà ngẫm nghĩ.
Đó cũng chính là những gì Alexander Fleming đã thực hiện gần trăm năm về trước.
Tham khảo ZDnet
NỔI BẬT TRANG CHỦ
-
Apple và MCK hợp tác thực hiện album trailer 360 độ quay bằng 8 chiếc iPhone 17 Pro
Album trailer "HVL" của MCK được thực hiện bằng 8 chiếc iPhone 17 Pro gắn trên rig chuyên dụng, đồng bộ qua genlock để tạo trải nghiệm 360 độ tương tác - lần đầu tiên một nghệ sĩ Việt hợp tác quy mô này cùng Apple.
-
Bí mật đằng sau album trailer "HVL" của MCK: 8 chiếc iPhone 17 Pro và kỹ thuật quay 360 độ “thế giới chưa ai từng làm”